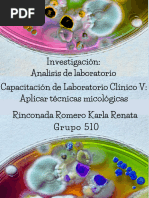

100% encontró este documento útil (1 voto)
224 vistas16 páginasIdentificación de Staphylococcus epidermidis
El documento describe Staphylococcus epidermidis, una bacteria comúnmente encontrada en la piel humana. S. epidermidis generalmente no causa enfermedades, pero puede causar infecciones en implantes médicos como catéteres y prótesis. Produce biopelículas que le permiten adherirse a estos dispositivos e infectarlos, lo que dificulta el tratamiento debido a su resistencia a múltiples antibióticos.
Cargado por
Itzel MercadoDerechos de autor
© © All Rights Reserved
Nos tomamos en serio los derechos de los contenidos. Si sospechas que se trata de tu contenido, reclámalo aquí.
Formatos disponibles
Descarga como PPT, PDF, TXT o lee en línea desde Scribd
100% encontró este documento útil (1 voto)
224 vistas16 páginasIdentificación de Staphylococcus epidermidis
El documento describe Staphylococcus epidermidis, una bacteria comúnmente encontrada en la piel humana. S. epidermidis generalmente no causa enfermedades, pero puede causar infecciones en implantes médicos como catéteres y prótesis. Produce biopelículas que le permiten adherirse a estos dispositivos e infectarlos, lo que dificulta el tratamiento debido a su resistencia a múltiples antibióticos.
Cargado por
Itzel MercadoDerechos de autor
© © All Rights Reserved
Nos tomamos en serio los derechos de los contenidos. Si sospechas que se trata de tu contenido, reclámalo aquí.
Formatos disponibles
Descarga como PPT, PDF, TXT o lee en línea desde Scribd